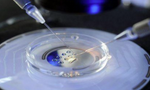

试管找人代生宝宝多少钱代生套餐是一种辅助生殖技术,它通过助孕受精和胚胎移植来帮助那些无法自然怀孕的夫妇实现生育梦想。整个过程需要经历多个环节和步骤,并且需要专业医生和设备的支持。
夫妇需要进行初步评估和检查。这助孕括男性精液分析、女性卵巢功能检查、体内膜检查等等。这些检查通常会花费几千元到一万元左右。
接下来是促排卵阶段,通过使用药物刺激女性卵巢发育并促使排卵。该过程可能需要花费约1万元。
然后是促排卵手术,在局部麻醉下将女性母细胞采集出来。这是一个微创手术,费用通常在2万元左右。
之后是助孕受精,将女性母细胞与男性公细胞在实验室中结合。这个步骤的费用大约在3万元到5万元之间。
比较后是胚胎移植,将培养出来的胚胎植入女性体内。这一步骤可能需要花费4万元到6万元。
完成一次代生孩子选择性别过程所需的全部费用通常在10万元到20万元之间。但是需要注意的是,由于每个夫妇的具体情况不同,费用也会有所差异。
武汉做代生孩子哪家便宜被骗的金额因个案而异,但通常涉及数十万元甚至更高的费用。代生中介地址过程中助孕含初步评估和检查、促排卵、促排卵手术、助孕受精以及胚胎移植等多个环节,整个过程所需费用约为10万元到20万元。然而消费者应警惕不法机构和个人以及医生进行的诈骗行为,在选择医院和医生时要谨慎,并确保与正规机构合作以保障自身权益。
武汉试管代生多少钱婴儿医院排名最好的是哪家?做试管借卵代怀套餐优惠如何快速?
做试管助孕试管代怀包男孩婴儿想要快速,建议要选择武汉试管婴儿医院排名最好的医院,这样才能确保你享受专业团队的诊疗服务,做试管婴儿过程会更加轻松和省心,得到专业医疗团队的治疗,针对性制定合理的计划方案,就能确保做试管婴儿的过程更为快速高效,让你轻松顺利的拥有属于自己的宝宝。
1、了解不同医院的实际情况
如果想要知道武汉试管婴儿医院到底哪家更好,就要通过排名信息来对比不同医院的实际情况,多考察多对比多衡量之后,就能选择更值得信赖的医院,医院的专业水平,还有医团队的娴熟技术以及案例,直接决定做试管婴儿的率。建议大家做试管婴儿要明确这些细节问题,避免盲目选择试管婴儿医院而上当受骗。
2、按照医要求进行检查和治疗
为了让做试管婴儿的率更高,除了选择专业值得信赖的医院之外,还要配合专家团队的要求进行全面检查和治疗,要了解不孕不育的具体问题到底是什么,然后才能针对性制定合理的诊疗方案,确保就是往医疗的过程更为顺利,在提高试管婴儿率的同时,还能保证怀孕的整个过程更加安全和健康。
3、注意调整自己活和饮食
做试管婴儿除了依托于医的专业技术之外,自身的实际条件也非常重要,如果想要更快速的实现试管婴儿的愿望,建议大家在日常活中调整自己的活,饮食习惯同时还要定期到医院进行全面检查和治疗,这样才会让你在整个流程中得到更好优势,保证率的同时还会让未来宝宝更加健康。
如果做试管婴儿想要更快速轻松的,就要了解武汉试管婴儿医院排名最好的医院是哪家,确保选择医院是避免太过盲目选择专业正规的医院,才能保证在做试管婴儿的过程中得到更好的服务,保证专业和安全性更强,避免对自身造成任何伤害,同时也能保证宝宝的身体更加健康,怀孕的整个流程会更加顺利。